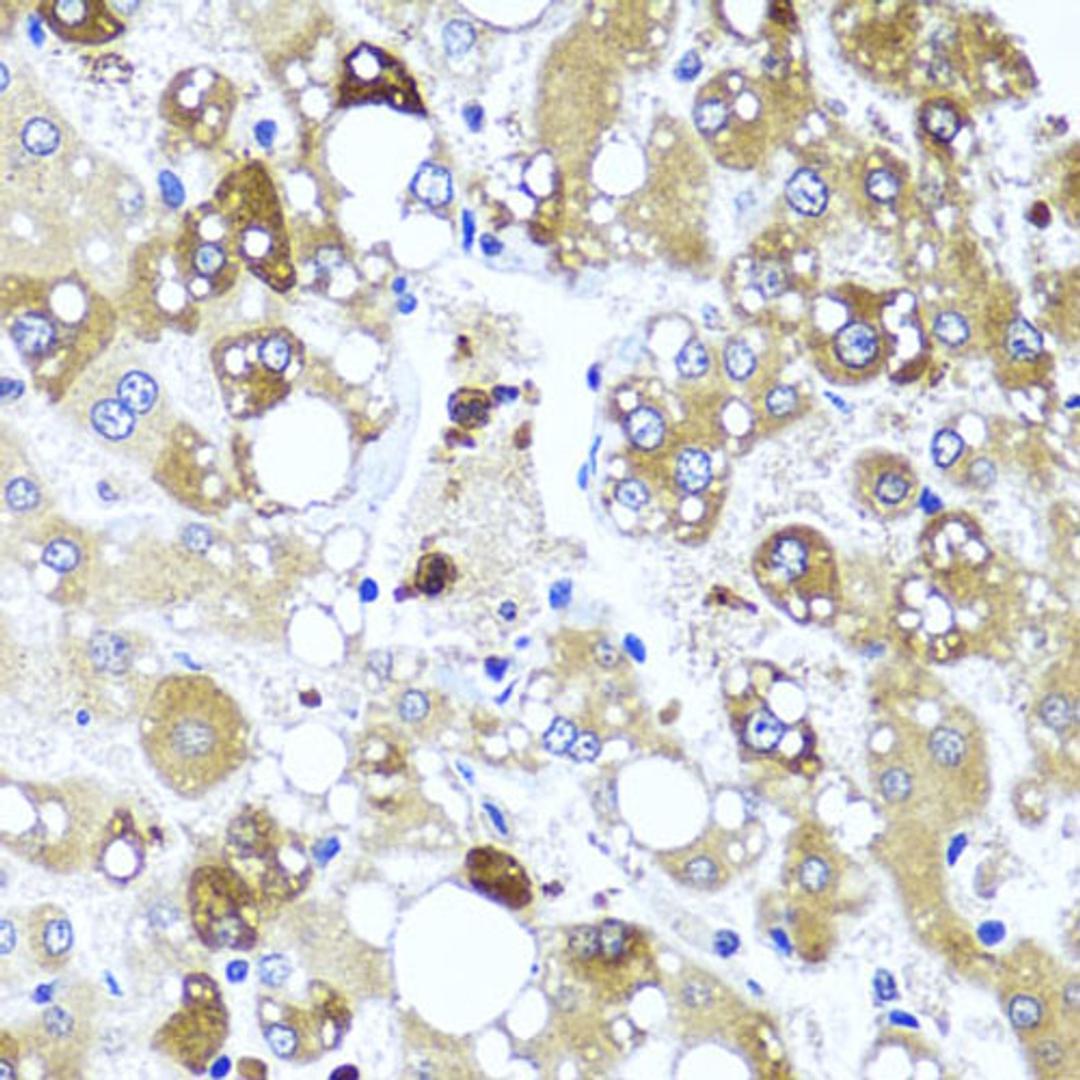
Immunohistochemistry - IL4 antibody (A5649)
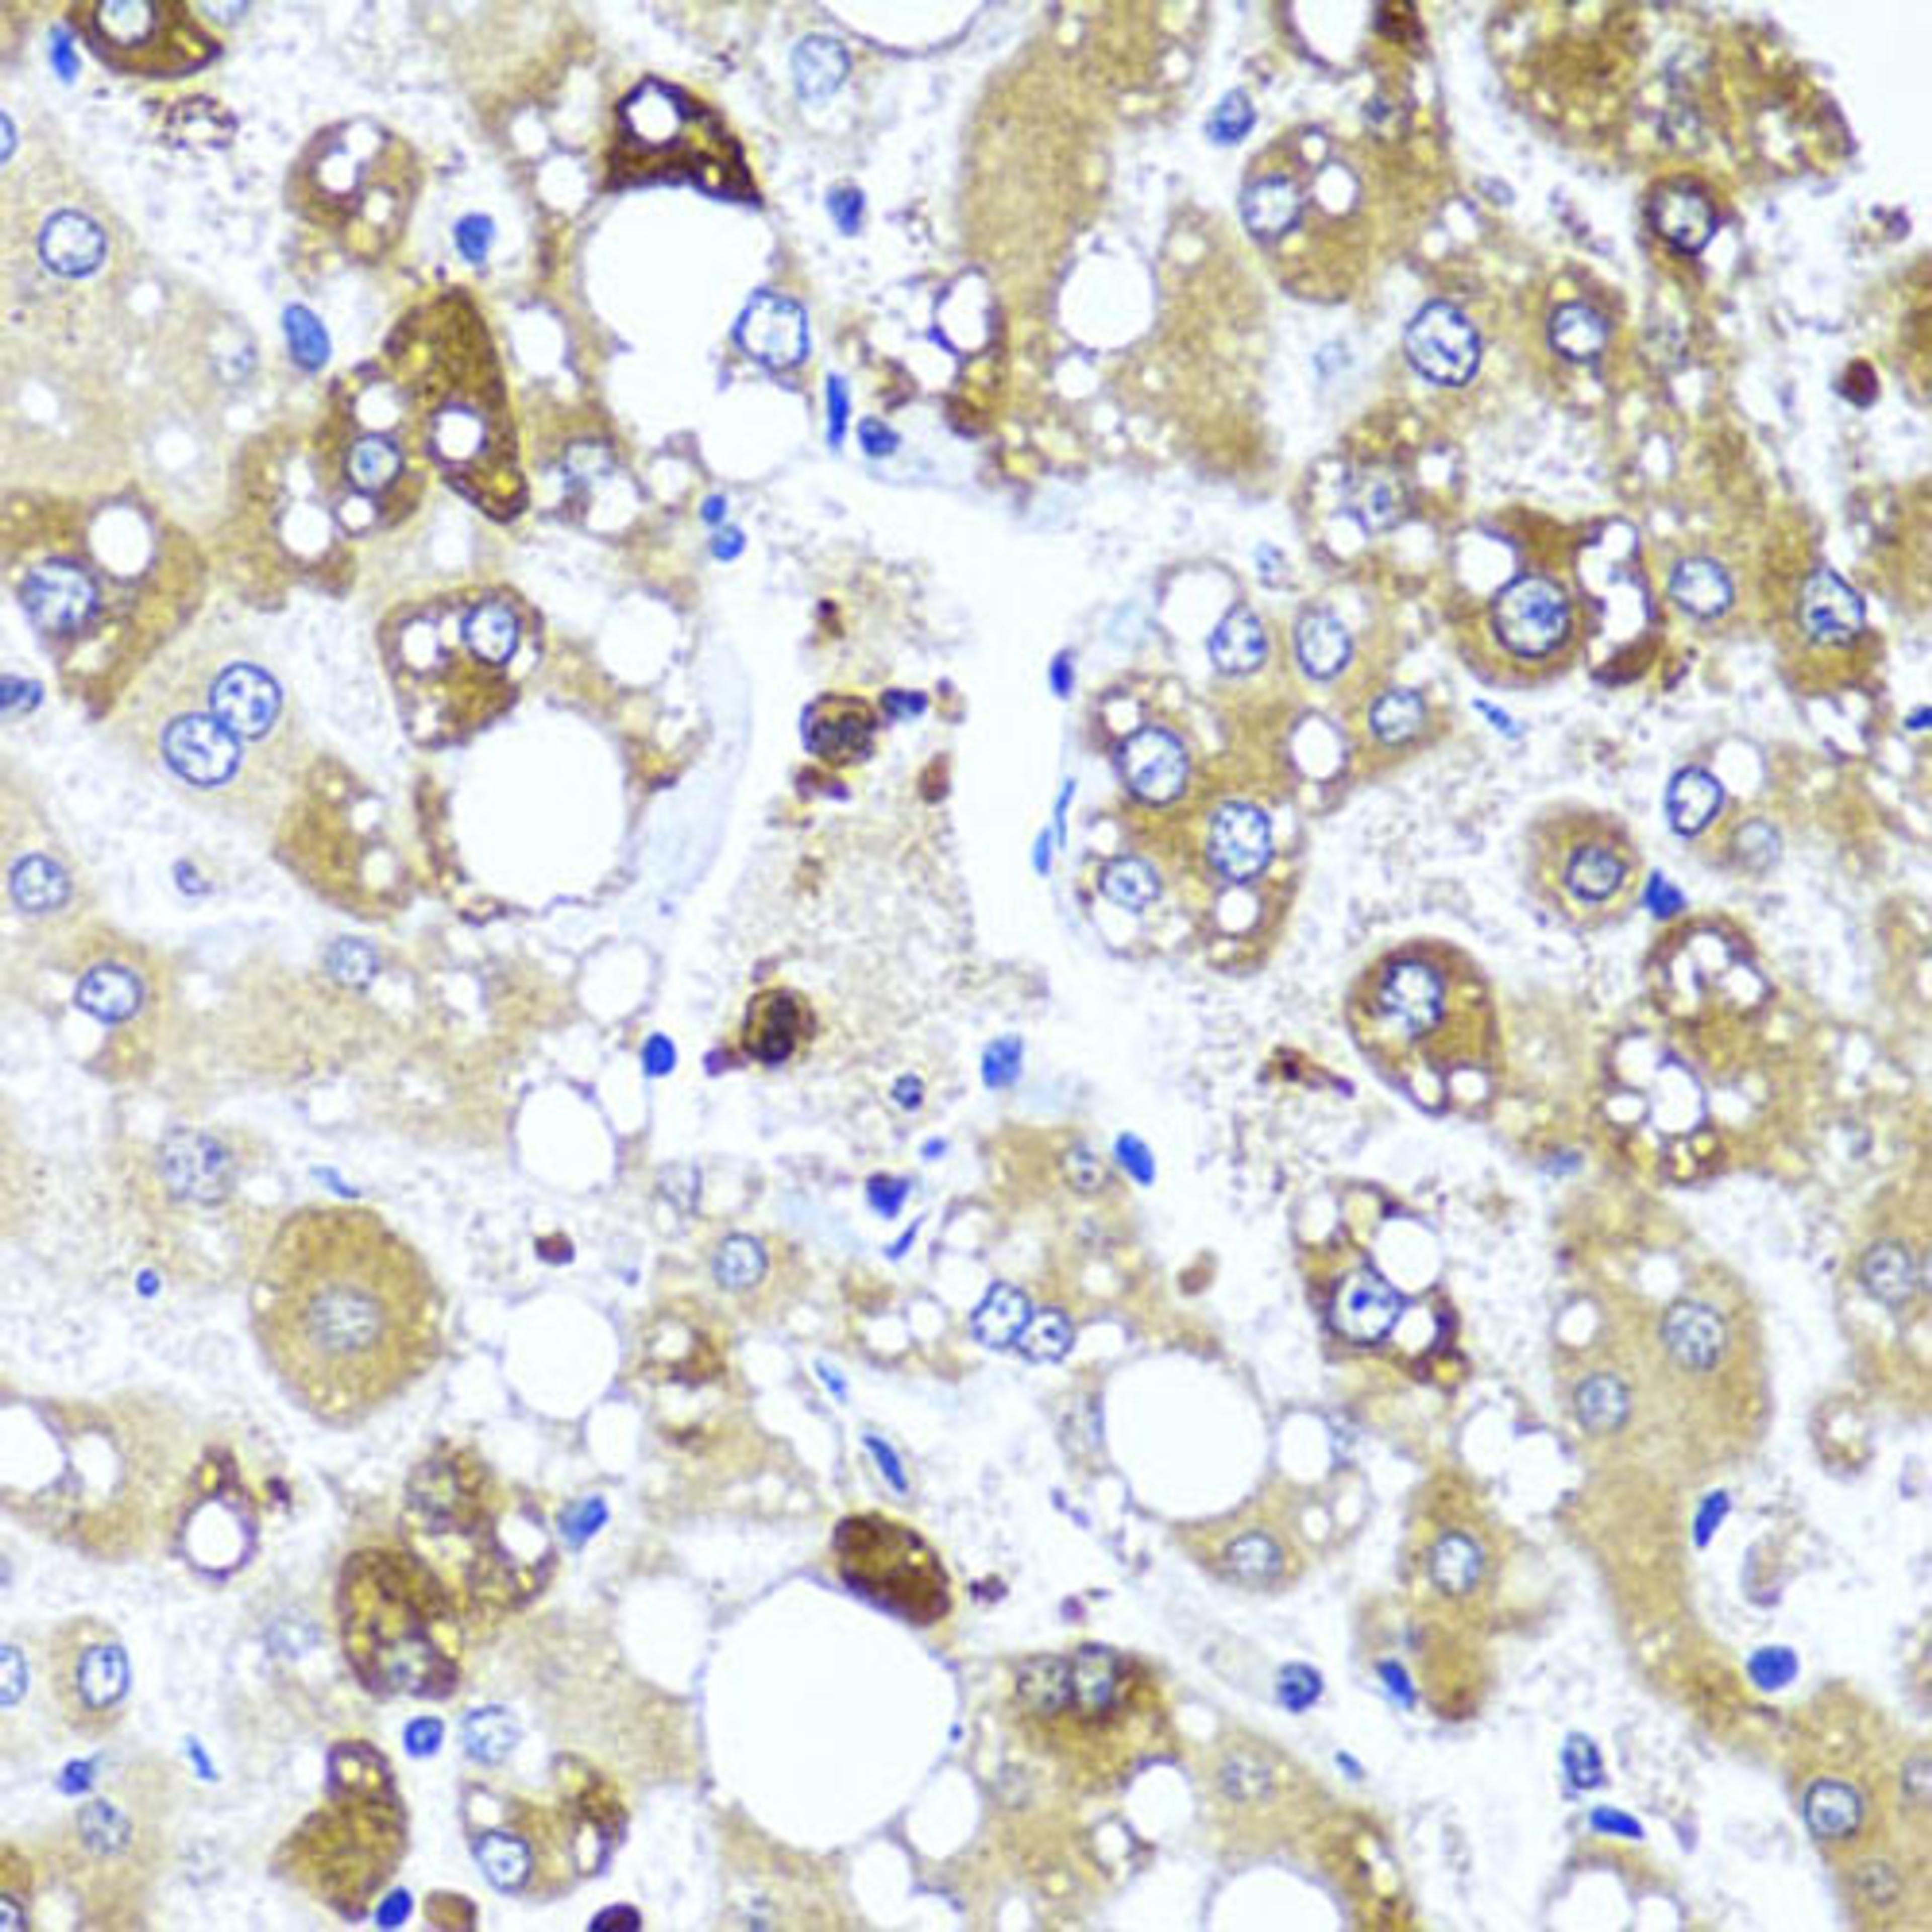
Immunohistochemistry - IL4 antibody (A5649)

IL4 Rabbit pAb
Product Details
- Cat. No.
- A5649
- Type
- Primary Antibody
- Clonality
- Polyclonal
- Host
- Rabbit

The supplier does not provide quotations for this antibody through SelectScience. You can search for similar antibodies in our Antibody Directory.
Description
The protein encoded by this gene is a pleiotropic cytokine produced by activated T cells. This cytokine is a ligand for interleukin 4 receptor. The interleukin 4 receptor also binds to IL13, which may contribute to many overlapping functions of this cytokine and IL13. STAT6, a signal transducer and activator of transcription, has been shown to play a central role in mediating the immune regulatory signal of this cytokine. This gene, IL3, IL5, IL13, and CSF2 form a cytokine gene cluster on chromosome 5q, with this gene particularly close to IL13. This gene, IL13 and IL5 are found to be regulated coordinately by several long-range regulatory elements in an over 120 kilobase range on the chromosome. Two alternatively spliced transcript variants of this gene encoding distinct isoforms have been reported.
Biological Information
- Clonality: Polyclonal
- Host: Rabbit
- Reactivity: Human